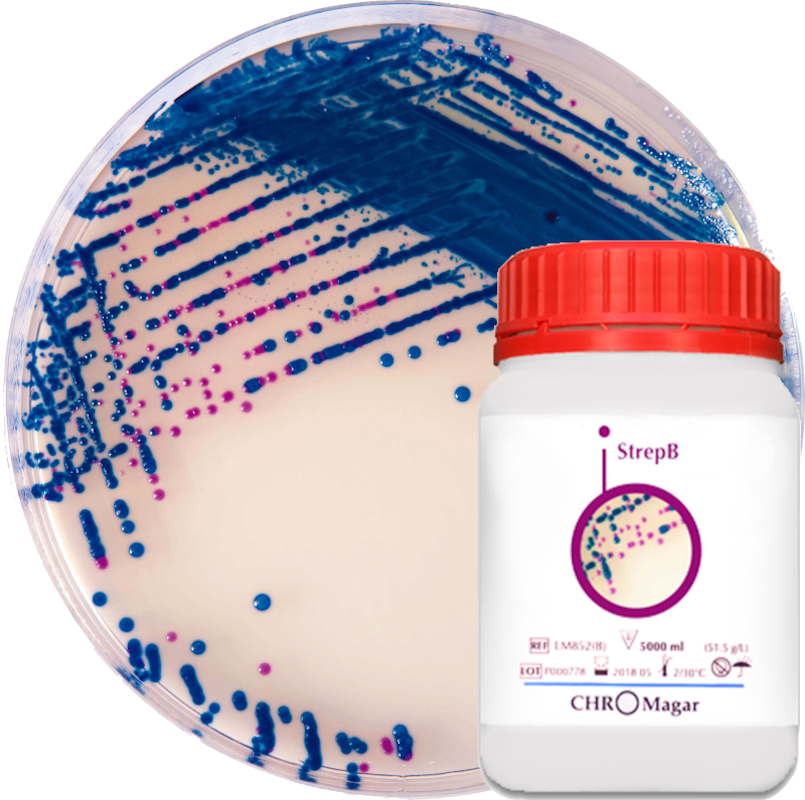
CHROMagar™ StrepB

24930000-2 Фотохімікати
Назва категорії: Живильні середовищаОдиниці виміру: штука
Технічні характеристики
Вид
Відповідність ДСТУ EN ISO 11133:2014
Фасування
Основа складу
Знайдено: 253

Агар Сальмонела-Шигела / S.S. AGAR, Sanimed-M

Бульйон цистин-селенітовий, 4020262

Агар з емульсією яєчного жовтка, 50%, селективнинй компонент, 42111605
CHROMagar™ StrepB

Лактобакагар/LAKTOBAC AGAR, Sanimed-M

Агар Сабуро з хлорамфеніколом Sanimed-M

Бульйон Мюллера-Кауфмана тетратіонатний (MKTT), селективний компонент, 4240047

Бульйон Фрейзера первинного збагачення, 4014952+4240044

Агар МакКонкі з кристалвіолетом і 0,15% жовчних солей /MACCONKEY AGAR w/ CV, NaCl AND 0,15% BILE SALTS, Sanimed-M

Жовчні солі Sanimed-M

Глюкозо – фосфатний бульйон, Кларка/ GP BROTH, Sanimed-M
